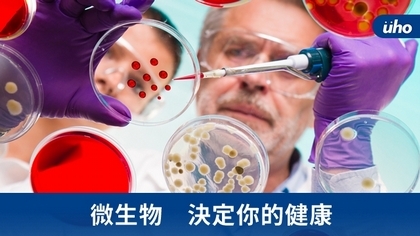
微生物　決定你的健康

(優活健康網記者黃苡安/綜合報導)吃飯隨便吃吃就好?其實吃不好不只是人體的腸道會出狀況,連大腦也會被影響,越來越多研究證實腸道內微生物能影響大腦功能及情緒。醫師指出,腸胃道跟大腦有連結,越來越多證據顯示憂鬱、焦慮、自閉症、帕金森氏症都跟腸道微生物狀況有關。若想調整腸道微生物的話,擁有健康飲食習慣、良好作息才是關鍵!腸道健康與精神疾病大有關聯大腦跟腸道看似兩個不同部位竟然也有關聯性?主要是腸道微生物群在腸道發揮著重要作用,聯安診所院長、肝膽腸胃科醫師鄭乃源解釋:「腸胃道跟大腦本來就有連結,是雙向溝通,腸腦軸線的概念,是人體內大腦、腸道和腸道菌共同構成的系統。」你一定有過緊張到胃痛、壓力大拉肚子、心情不好想大吃,其實這就是「大腦」跟「腸道」互相影響,兩者互相傳導訊號。加上腸道掌控重要的消化功能,擁有一套獨立自主神經、內分泌、免疫系統,被譽為人類「第二大腦」,腸道微生物可透過代謝物如︰短鏈脂肪酸、色胺酸、血清素等,及迷走神經與腦部做溝通、影響腸道神經敏感性、蠕動及荷爾蒙的分泌。越來越多的研究支持這樣的論點,科學家指出許多「消化性疾病」與「腦部疾病」是有密切關聯性,鄭乃源舉例,帕金森氏症主要病理就是α-突觸核蛋白,科學家發現來源就是腸道,當腸道如果有發炎,微生物會去製造α-突觸核蛋白,它便會一路從迷走神經跑到大腦,造成帕金森氏症。此外,研究學者也發現帕金森氏症患者常常有腸胃症狀,且這些症狀是在患者被確診帕金森氏症之前就有了,也再次證實大腦跟腸道的密切性。許多腸胃道疾病患者,像是胃潰瘍、腸躁症者,也同時有大腦功能失調、記憶力下降、睡眠品質不良等問題。腸道微生物功用百百種好的腸道環境影響著大腦的健康,那就不能不了解腸道內的微生物,過往科學家對於微生物了解並不多,直到近年才發現,人類的胃腸內有上百兆個微生物,包括細菌、真菌和病毒,大多分布在大腸中。好的微生物對於人體是非常有貢獻,會幫助人體處理食物、代謝藥物、訓練免疫系統、抵禦致病病原、分泌傳導物質像是血清素等重要的功能。因此不管是想要有好的健康狀態、清晰的大腦,還是穩定的情緒,都需要顧好自己的腸道菌,而腸道菌的影響關鍵則在於飲食。鄭乃源表示:「腸道菌種類非常多,要以生態系的概念去看,而生態系生長的樣態會跟腸道得到的養分相關,常吃纖維、蔬食對腸道生態較為有利。」挑選對的食物、正確的飲食方式有很大幫助,可分成兩種方式進行:*健康飲食習慣:從飲食上做調整,多吃天然蔬食、纖維類,避免加工類的食品。容易有腸胃道症狀的人,建議從飲食中找出哪些食物較易引起不適,可採取低FODMAP飲食原則。「FODMAP」是指存在於天然食材的短鏈碳水化合物及糖醇,屬於益生質的一種,這類食物經過腸道細菌發酵,對於某些人會產生氣體並引起腹脹、腹痛,比較敏感族群可以避開這類食物。*補充益生菌:不同的益生菌株有各自功能,像是格氏乳桿菌可以幫助腸胃消化、保護腸黏膜;雷特氏雙歧桿菌有效改善便秘、降血壓、膽固醇等,民眾可以選擇適合自己的益生菌。腸道微生物有生理時鐘 良好生活作息不能少除了飲食之外,生活型態也會影響腸道微生物,鄭乃源提醒。腸道微生物也有生理時鐘,熬夜、失眠也都會連帶會影響,包含壓力過大也是。不良生活的習慣,抽菸、喝酒、環境毒素、除草劑、殺蟲劑不利於培養好的腸道環境。